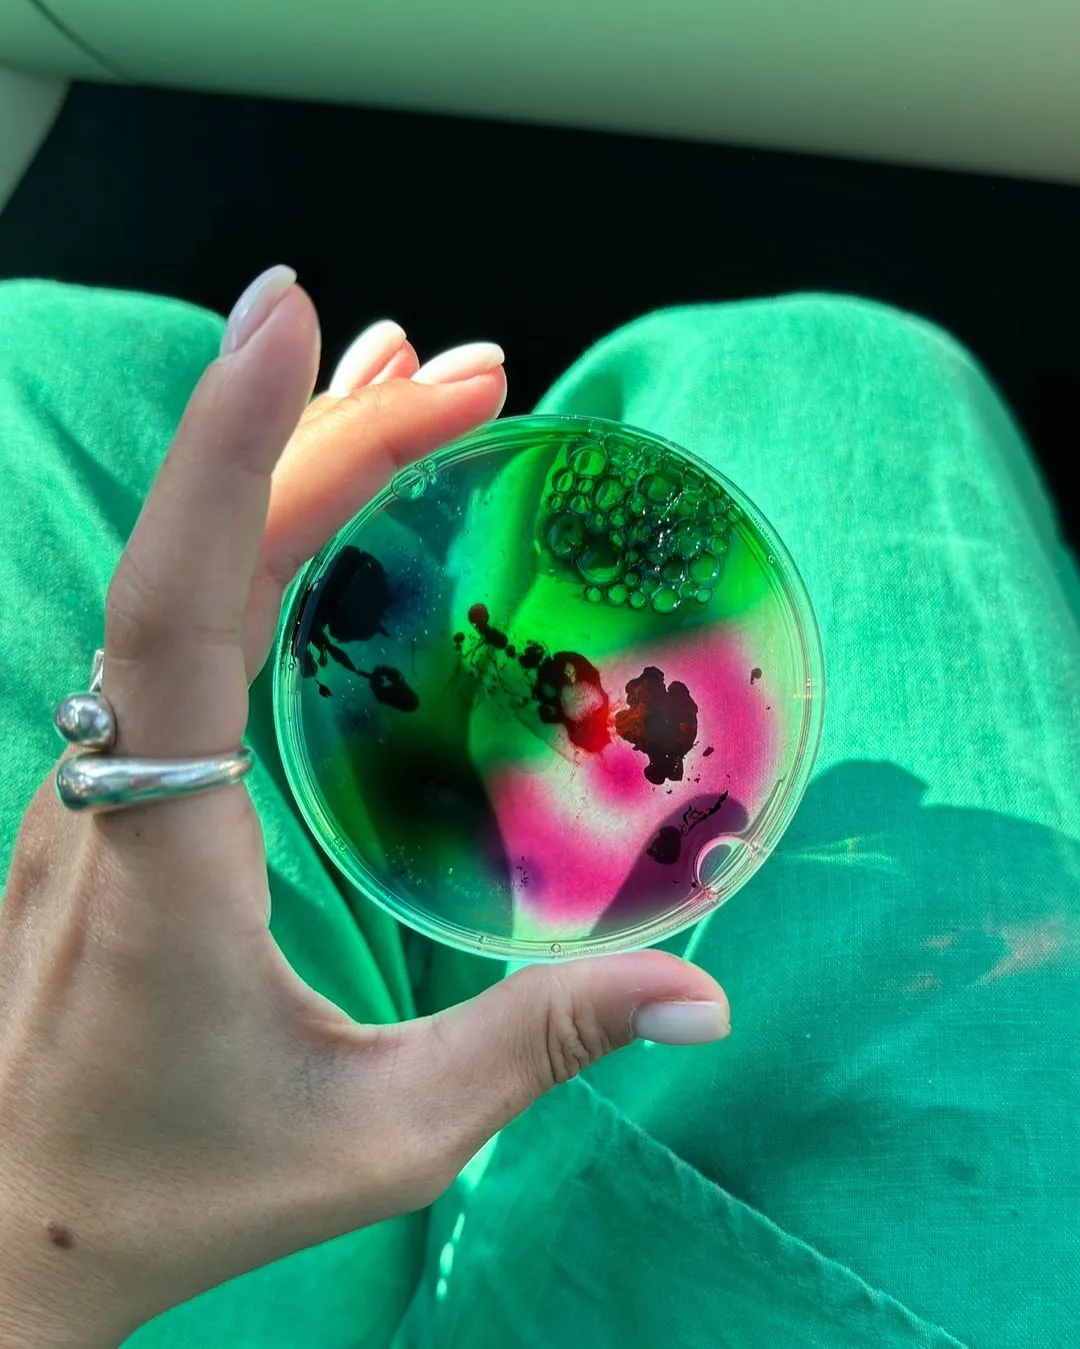
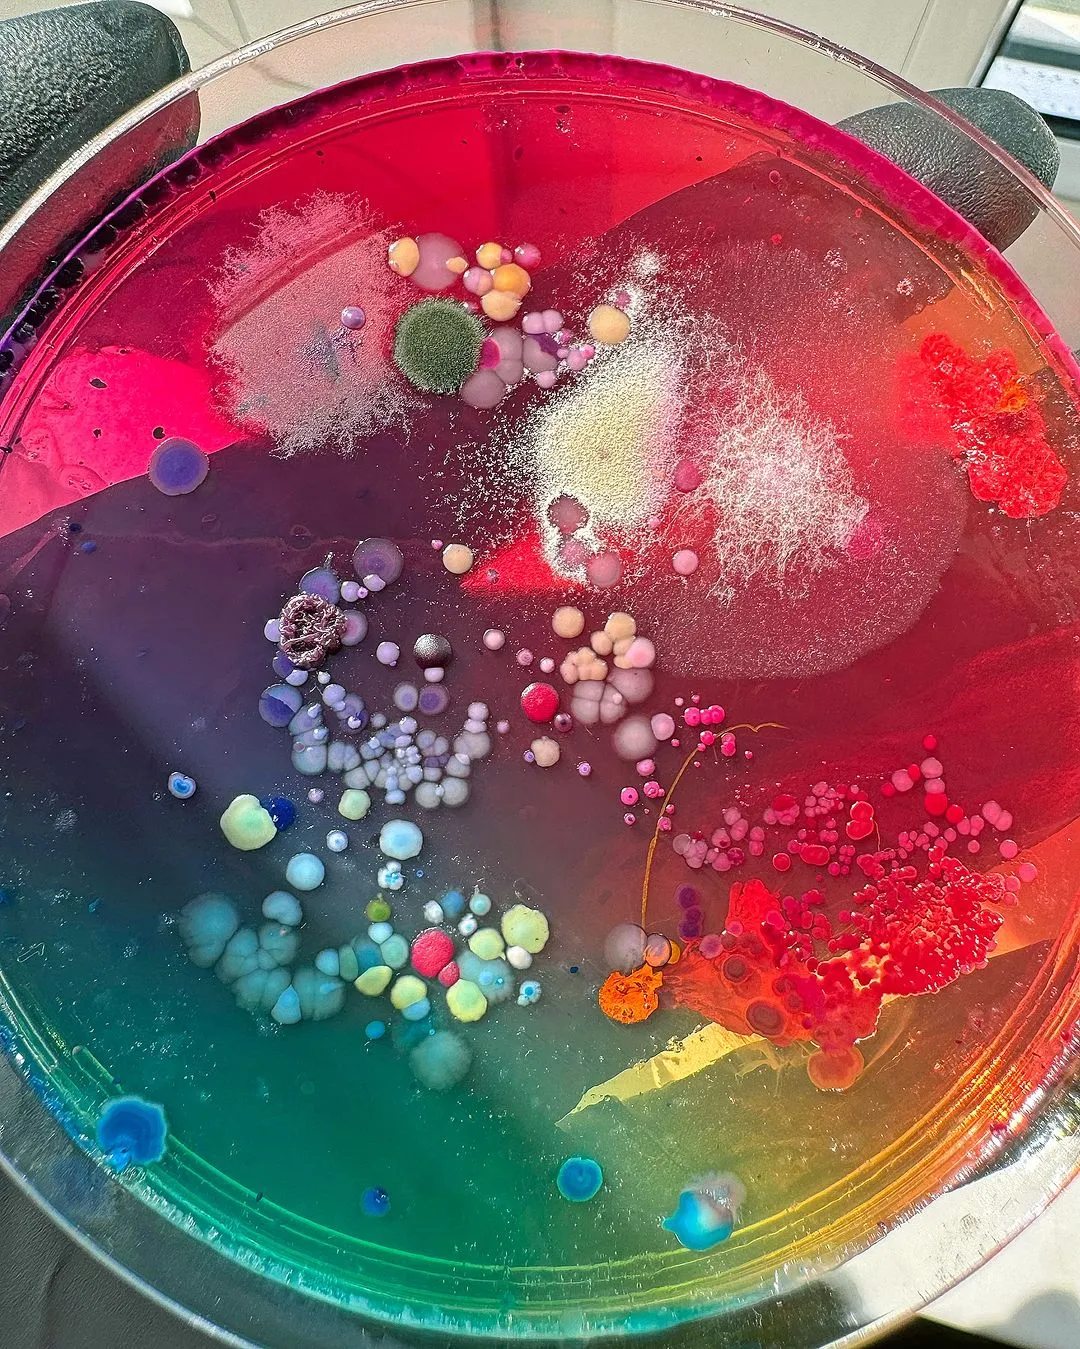
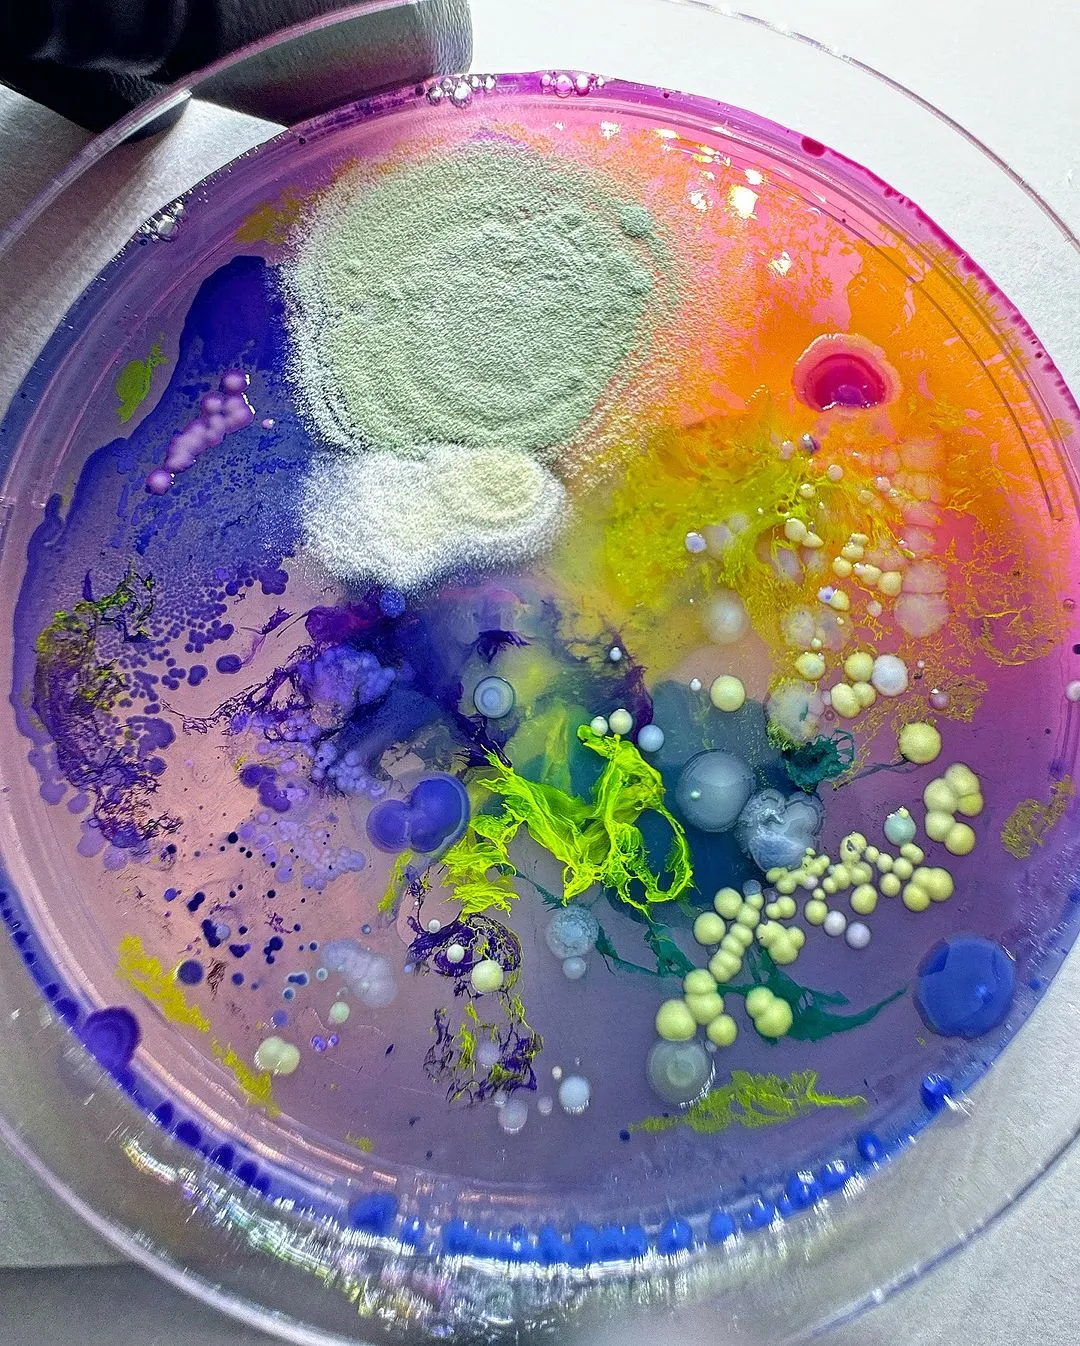
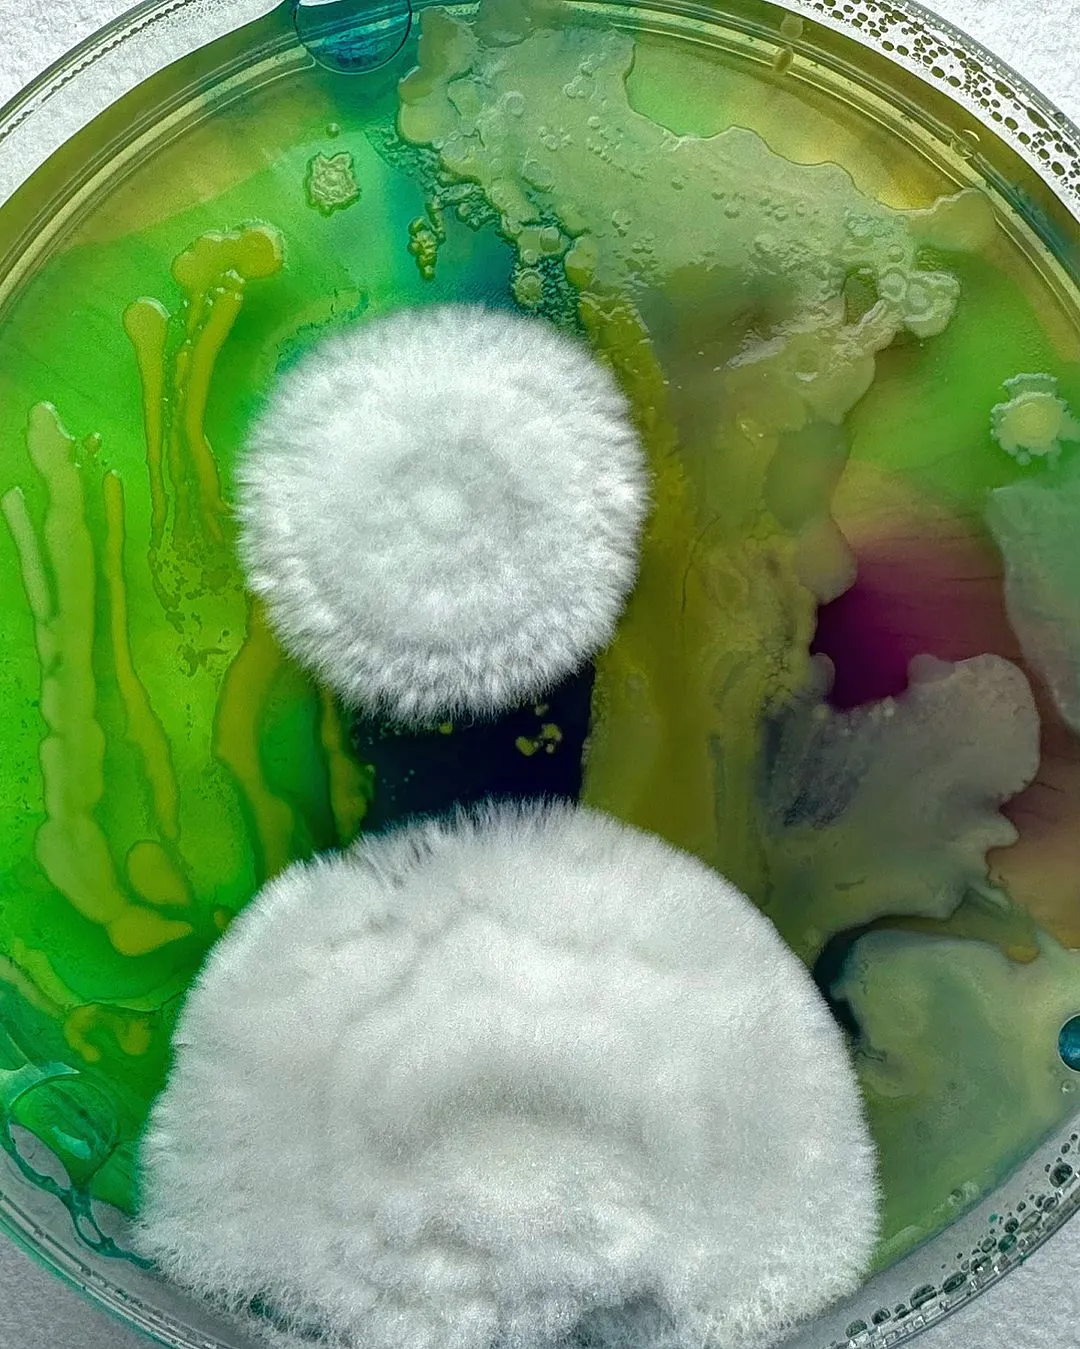

“เท้าเชื้อรา” คำนี้อาจฟังดูไม่ค่อยอภิรมย์นัก เพราะราแสดงถึงความสกปรก อับชื้น และถูกเก็บมาเป็นเวลานาน ข้อมูลในเชิงลบแบบนี้ทำให้คนส่วนใหญ่มีภาพจำเกี่ยวราที่ไม่ได้สวยงาม แต่คนส่วนน้อยอาจมองว่าเชื้อรามีเสน่ห์และมีมิติอันล้ำลึกเชิงศิลปะอย่างไม่น่าเชื่อ สิ่งนี้เกิดขึ้นกับ Dasha Plesen ศิลปินจากกรุงมอสโกที่มีมุมมองกับราในรูปแบบที่แตกต่าง และเธอยังเป็นใช้เอกลักษณ์ความสวยงามของมันรังสรรค์จนเกิดเป็นงานศิลปะอันแปลกใหม่ไม่เหมือนใคร นำมาสู่ความน่าสนใจที่ผนวกเอาวิทยาศาสตร์และศิลปะเข้าไว้ด้วยกันอย่างไม่น่าเชื่อ
‘ราชินีแห่งเชื้อรา’ ฉายานี้คือสิ่งสะท้อนความสนใจและรูปแบบการสร้างสรรค์ผลงานของดาช่าได้เป็นอย่างดี ซึ่งผลงานชิ้นสะดุดตาที่ทำให้ผู้เขียนประทับใจและยังเชื่อมโยงกับมิติด้านศิลปะแฟชั่น คือผลงานรองเท้าเชื้อรา ตลอดระยะเวลาการพัฒนาผลงานของเธอเต็มไปด้วยวิธีการผสมผสานระหว่างสิ่งมีชีวิตขนาดเล็กจิ๋วกับความคุ้นเคยที่เป็นประสบการณ์ร่วมของทุกคน รองเท้าส้นสูงคู่นี้ถูกปกคลุมไปด้วยเชื้อรา ทว่ามันไม่ใช่ความเก่าเก็บไร้การรักษา ดาช่าเพาะเชื้อราขึ้นแบบมาจากถาดทดลอง มาถึงจุดนี้หากจะพูดว่าเธอคือส่วนผสมระหว่างศิลปินและนักวิทยาศาสตร์คงไม่ผิดนัก
เอกลักษณ์ในผลงานของดาช่าคือการเสริมสร้างวิธีการพัฒนาเชิงวิทยาศาสตร์มาใช้ร่วมกับเทคนิคการสร้างงานศิลปะ เธอจึงได้รับการนิยามว่าเป็น ‘Bio Artist’ หรือ ‘ศิลปินเชิงชีวภาพ’ ซึ่งเธอพัฒนาเทคนิควิธีการเพาะเลี้ยงจุลินทรีย์และเชื้อรารูปแบบต่างๆ ล้ำลึกถึงการศึกษาปฏิกิริยาตอบสนอง เพื่อค้นหาผลิตภัณฑ์เสริมในการปรับเปลี่ยนรูปแบบของการเพาะเลี้ยงให้มีความซับซ้อน และนำมาสู่มิติความสวยงามที่เมื่อพูดถึงเชื้อราอาจไม่เคยมีใครคิดถึงมาก่อน ผลงานรองเท้าส้นสูงก็เช่นกัน ความแฟนตาซีเหนือจริงจากสีสัน ลวดลาย และรายละเอียดพื้นผิวนั้นพิเศษและไม่มีทางจะลอกเลียนแบบได้เลยแม้แต่น้อย ซึ่งดาช่าเองก็อาจผลิตซ้ำให้เกิดลวดลายเดิมเป๊ะๆ ไม่ได้อีกแล้ว
งานจุลชีววิทยากับโลกศิลปะเกี่ยวข้องกันอย่างน่าสนใจ เพราะวิธีการเพาะเลี้ยงเชื้อราของดาช่าทำให้เกิดปรากฏการณ์เชิงศิลป์ ประกอบด้วยรูปแบบของผลงานที่หลากหลาย เต็มไปด้วยกลิ่นอายที่แตกต่าง ไม่ว่าจะเป็น ความโรแมนติก ความแปลกพิสดาร การเสียดสี ความเหนือจริง และอื่นๆ อีกมากมาย ซึ่งทั้งหมดสะท้อนออกมาผ่านการเจริญเติบโตของสิ่งมีชีวิตขนาดจิ๋วในถาดเพาะเชื้อ โดยมีเบื้องหลังเป็นกระบวนการคิดทดลองของดาช่าที่เจาะลึกถึงรายละเอียดอย่างเข้มข้นจนสามารถเนรมิตผลงานเชื่อมโยงด้วยสัญญะทางศิลปะได้อย่างมีนัยสำคัญ
“การทำงานกับวัสดุซึ่งไม่ง่ายนักในการเก็บรักษาทำให้คุณรู้สึกถึงความสำคัญของกระบวนการทางธรรมชาติที่คุณไม่สามารถทำซ้ำได้” ดาช่ากล่าวถึงการทำงานผสมผสานระหว่างวิทยาศาสตร์และศิลปะ ความน่าสนใจอีกมุมหนึ่งของผลงานศิลปะจากเชื้อราคือกระบวนการก่อนจะเกิดผลลัพธ์ เพราะอย่างที่กล่าวไปว่าการเจริญเติบโตของสิ่งมีชีวิตเล็กๆ เหล่านี้มีความแตกต่าง แม้จะใช้สูตรสำเร็จเดียวกัน แต่ก็ปฏิเสธไม่ได้ว่ามันก็แตกต่างและดึงดูดความสนใจทุกครั้ง สะท้อนภาพของชีวิตมนุษย์บางคนที่อาจเหมือน แต่แท้จริงแล้วก็มีความแตกต่างกันไม่มากก็น้อย และนี่คือผลงานศิลปะที่ทำให้เราสะดุดตาตั้งแต่พบเห็น อย่างเช่นรองเท้าเชื้อรา เป็นต้น ก่อนจะยิ่งรู้สึกประทับใจขึ้นอีกระดับเมื่อเจาะลึกถึงกระบวนการเบื้องหลัง ใครอ่านบทความนี้แล้วอยากชมผลงานของดาช่าเพิ่มเติม สามารถคลิกชมได้ที่ @dashaplesen
ภาพ: Dasha Plesen